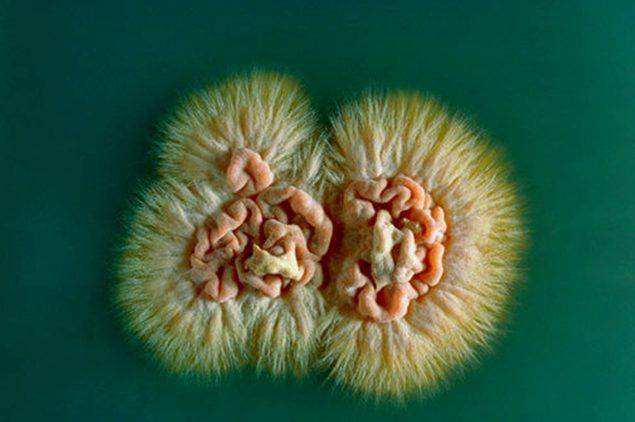
грибок
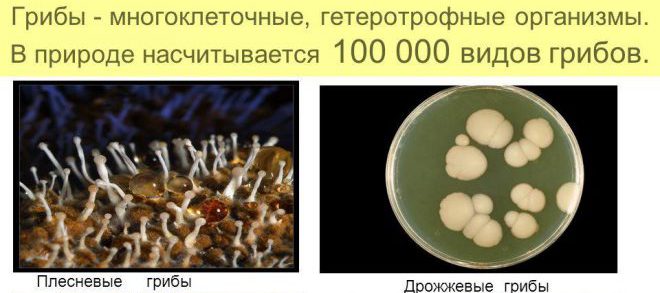
диагностика грибка

Грибки – микроорганизмы, множество из которых «проживают» в человеческом теле. Пока «хозяин» здоров, они никак себя не проявляют и даже приносят пользу, но стоит здоровью хоть немного пошатнуться, как грибковая инфекция начинает активно развиваться, вызывая различные заболевания (микозы).
Как можно заразиться грибками
По месту расположения обозначаются два вида грибков: наружный – проявляющий себя на волосистой части головы, поверхности кожи, ногтей и слизистых, глубокий – распространяющийся в глубинные слои дермы, поражающий внутренние органы. Питанием для грибов в организме человека служат ткани, на которых они поселяются и постепенно уничтожают, обезображивая внешний вид носителя, имеет место образование гранулем на органах, что вызывает нарушение функциональности последних, аллергические реакции.
Врачи отмечают, что грибковые инфекции становятся все более распространенной проблемой в современном обществе. Они могут поражать различные части тела, включая кожу, ногти и внутренние органы. Специалисты подчеркивают, что ослабленный иммунитет, неправильное питание и частое использование антибиотиков способствуют развитию грибковых заболеваний. Важно своевременно диагностировать и лечить такие инфекции, так как они могут привести к серьезным осложнениям. Врачи рекомендуют соблюдать гигиену, избегать контакта с зараженными людьми и следить за состоянием здоровья, особенно при наличии предрасполагающих факторов. Профилактика и раннее обращение к специалистам играют ключевую роль в борьбе с грибковыми инфекциями.
https://youtube.com/watch?v=0ukpn-CUevE
Причины развития микозов

Существует немало разновидностей микозов, каждая из которых проявляется специфическими признаками, однако имеется и общая симптоматика, именно на нее чаще всего и обращает внимание человек.
Основные признаки наличия грибков у человека
Грибковые инфекции в организме человека вызывают множество обсуждений и мнений. Многие люди отмечают, что такие инфекции могут проявляться в самых разных формах, от кожных заболеваний до более серьезных системных инфекций. Часто упоминается, что ослабленный иммунитет, стресс и неправильное питание способствуют развитию грибков. Некоторые делятся личным опытом, рассказывая о том, как им удалось справиться с инфекцией с помощью медикаментов и народных средств. В то же время, существует мнение, что профилактика играет ключевую роль: соблюдение гигиенических норм и здоровый образ жизни могут значительно снизить риск заражения. Однако, несмотря на распространенность грибковых инфекций, многие люди все еще недостаточно информированы о симптомах и методах лечения, что подчеркивает важность образовательных программ и консультаций с врачами.
Наиболее распространенные грибковые патологии и их проявления
Бластомикоз

Проявляется красными маленькими гнойничками, высыпающими на руках и ногах, шее и лице. По мере развития заболевания прыщи увеличиваются в размерах, превращаются в болезненные изъязвления, грибок поражает печень, почки, ЦНС и селезенку, легкие. Лечение заболевания проводится при помощи антибиотиков – для легочной системы, йодида калия и лучевой терапии.
Гистоплазмоз

Патогенный микроорганизм содержится в птичьем помете, проникает в организм человека при прямом контакте или при вдыхании зараженного спорами воздуха, при поедании загрязненных продуктов. Изначально поражаются уши, носоглотка и полость рта с образованием ран, в это же время увеличиваются близлежащие лимфоузлы. В дальнейшем нарушается работа селезенки и печени, кишечник покрывается язвами. У больного в это время наблюдается повышение температуры, анализы крови показывают снижение лейкоцитов и эритроцитов.
Аспергиллез

Инфекция поражает слизистую носовых пазух, кожу, поверхность внутреннего уха. Симптомы заболевания —, боли, зуд и посерение кожных покровов, при проникновении в легкие возникают признаки, схожие с туберкулезом. Переносятся споры птицами, путь заражения – воздушный.
Кокцидиоидоз

Болезнь проявляется повышением температуры, кашлем и болями за грудиной, в дальнейшем возникает кожная сыпь с гнойным образованием. В большинстве случаев признаки исчезают самостоятельно, но иногда паразит проникает в оболочку мозга, суставы и кости, где образует язвы и гранулемы. Лечение болезни возможно лишь на начальной стадии, немного задержать развитие микоза может Амфотерицин.
Споротрихоз

Изначально кожа покрывается плотными узелковыми образованиями, через некоторое время превращающиеся в язвы, окруженные ореолом, цвет которого постепенно меняется с розового на черный. Узелки и язвы распространены произвольно, но в обязательном порядке располагаются на поверхности дермы напротив лимфоузлов. Дальше микотическая инфекция может охватить кости, слизистые, внутренние органы.
Криптококкоз

Проникают грибки в организм человека через пищеварительную или дыхательную систему, инфекция локализуется в тканях мозга и его оболочке, в некоторых случаях распространяется в иные органы, вызывая образование абсцессов и опухолей. При поражении мозга больной страдает от мигреней и головокружения, имеет место повышенный тонус мышц шеи, нарушение зрения и координации движений, при дальнейшем развитии болезни возможен паралич тела.
Кандидоз

Инфекция проникает в слизистую оболочку, ногтевые пластины и некоторые внутренние органы. Заражение происходит оральным путем, изначально вызывая молочницу слизистой рта. В дальнейшем развивается кандидоз половых органов, желудка, легких, пр.
Хромобластомикозы
Болезнь провоцирует образование множественных поражений кожи —, синевато-красных тканевых разрастаний бородавчатого типа, распространяющихся по всему телу. Затем грибок проникает в печень, мозг, легкие.
Дерматомикозы

Объемное поражение поверхностей тела (себорея, лишай разных видов, эпидермофитии стоп и пр.), проявляющееся в повышенной сухости и шелушении дермы, появлении пятен не характерного цвета, припухлостей, зуда.
Диагностика
Точно установить, к какому виду относиться грибок в организме человека, можно при помощи микологических исследований материала, люминесцентного свечения, анализов мочи и крови, ПЦР (выявляет вид возбудителя), мазка из половых органов. Направление на обследование выписывает врач, специальность которого определяется по симптомам заболевания – это может быть отоларинголог, гастроэнтеролог, гинеколог, фтизиатр, уролог.
Лечение грибка
Противомикозная терапия разрабатывается лечащим врачом в соответствии с разновидностью заболевания, возрастом и весом пациента, симптоматикой.

Дополнительно назначаются витаминные комплексы, желчегонные средства, иммунокорректоры, антиоксиданты, эубиотики, регуляторы микрофлоры кишечника (Хилак, Бактисубтил), ферменты (Фестал, Панкреатин), гепатопротекторы (Карсил, Липостабил, Эссенциале). Кроме того, проводится симптоматическая терапия.
В обязательном порядке больной должен придерживаться диеты: исключить углеводы (выпечку, макаронные изделия и крупы, сладости), отказаться от продуктов и напитков, содержащих дрожжи, а также жирной, острой, копченой и жареной пищи.
Чтобы помочь лекарствам бороться с микозами, можно применить народные средства, которые оказывают противогрибковый эффект —, употребление лука, чеснока, хрена, редьки, всех видов перца, куркумы, мускатного ореха, кориандра и пр. приправ, кислых ягод и живицы, кедрового, льняного и кунжутного масла пойдет на пользу всему организму.
https://youtube.com/watch?v=aS-6KH0q9X8
Вопрос-ответ
Каковы основные симптомы грибковых инфекций у человека?
Симптомы грибковых инфекций могут варьироваться в зависимости от типа инфекции и места ее локализации. Общие симптомы включают зуд, покраснение, отек, шелушение кожи, а также появление высыпаний или язв. В случае системных инфекций могут наблюдаться лихорадка, усталость и общая слабость.
Какие факторы способствуют развитию грибковых инфекций?
Развитию грибковых инфекций могут способствовать различные факторы, такие как ослабленная иммунная система, диабет, длительное использование антибиотиков, плохая гигиена, а также наличие хронических заболеваний. Также риск увеличивается при частом контакте с влажной средой, например, в бассейнах или саунах.
Как можно предотвратить грибковые инфекции?
Для предотвращения грибковых инфекций рекомендуется соблюдать личную гигиену, носить удобную и дышащую обувь, избегать контакта с зараженными людьми и местами, а также поддерживать иммунную систему в хорошем состоянии через правильное питание и физическую активность. Важно также своевременно лечить любые кожные повреждения и заболевания.
Советы
СОВЕТ №1
Регулярно поддерживайте гигиену кожи и ногтей. Чистота и сухость в области складок кожи, особенно в местах, где может скапливаться влага, помогут предотвратить развитие грибковых инфекций. Используйте антисептические средства и меняйте носки и обувь, чтобы снизить риск заражения.
СОВЕТ №2
Следите за своим питанием и иммунной системой. Употребление продуктов, богатых витаминами и минералами, особенно витаминами группы B и C, поможет укрепить иммунитет, что снизит вероятность развития грибковых инфекций. Избегайте избыточного потребления сахара, так как он может способствовать росту грибков.
СОВЕТ №3
Не игнорируйте симптомы. Если вы заметили покраснение, зуд, шелушение или другие необычные проявления на коже или ногтях, обратитесь к врачу. Раннее выявление и лечение грибковых инфекций значительно увеличивают шансы на быстрое выздоровление.
СОВЕТ №4
Избегайте использования чужих личных вещей. Такие предметы, как обувь, полотенца и маникюрные принадлежности, могут быть источниками грибковых инфекций. Используйте только свои вещи и старайтесь не делиться ими с другими людьми.

